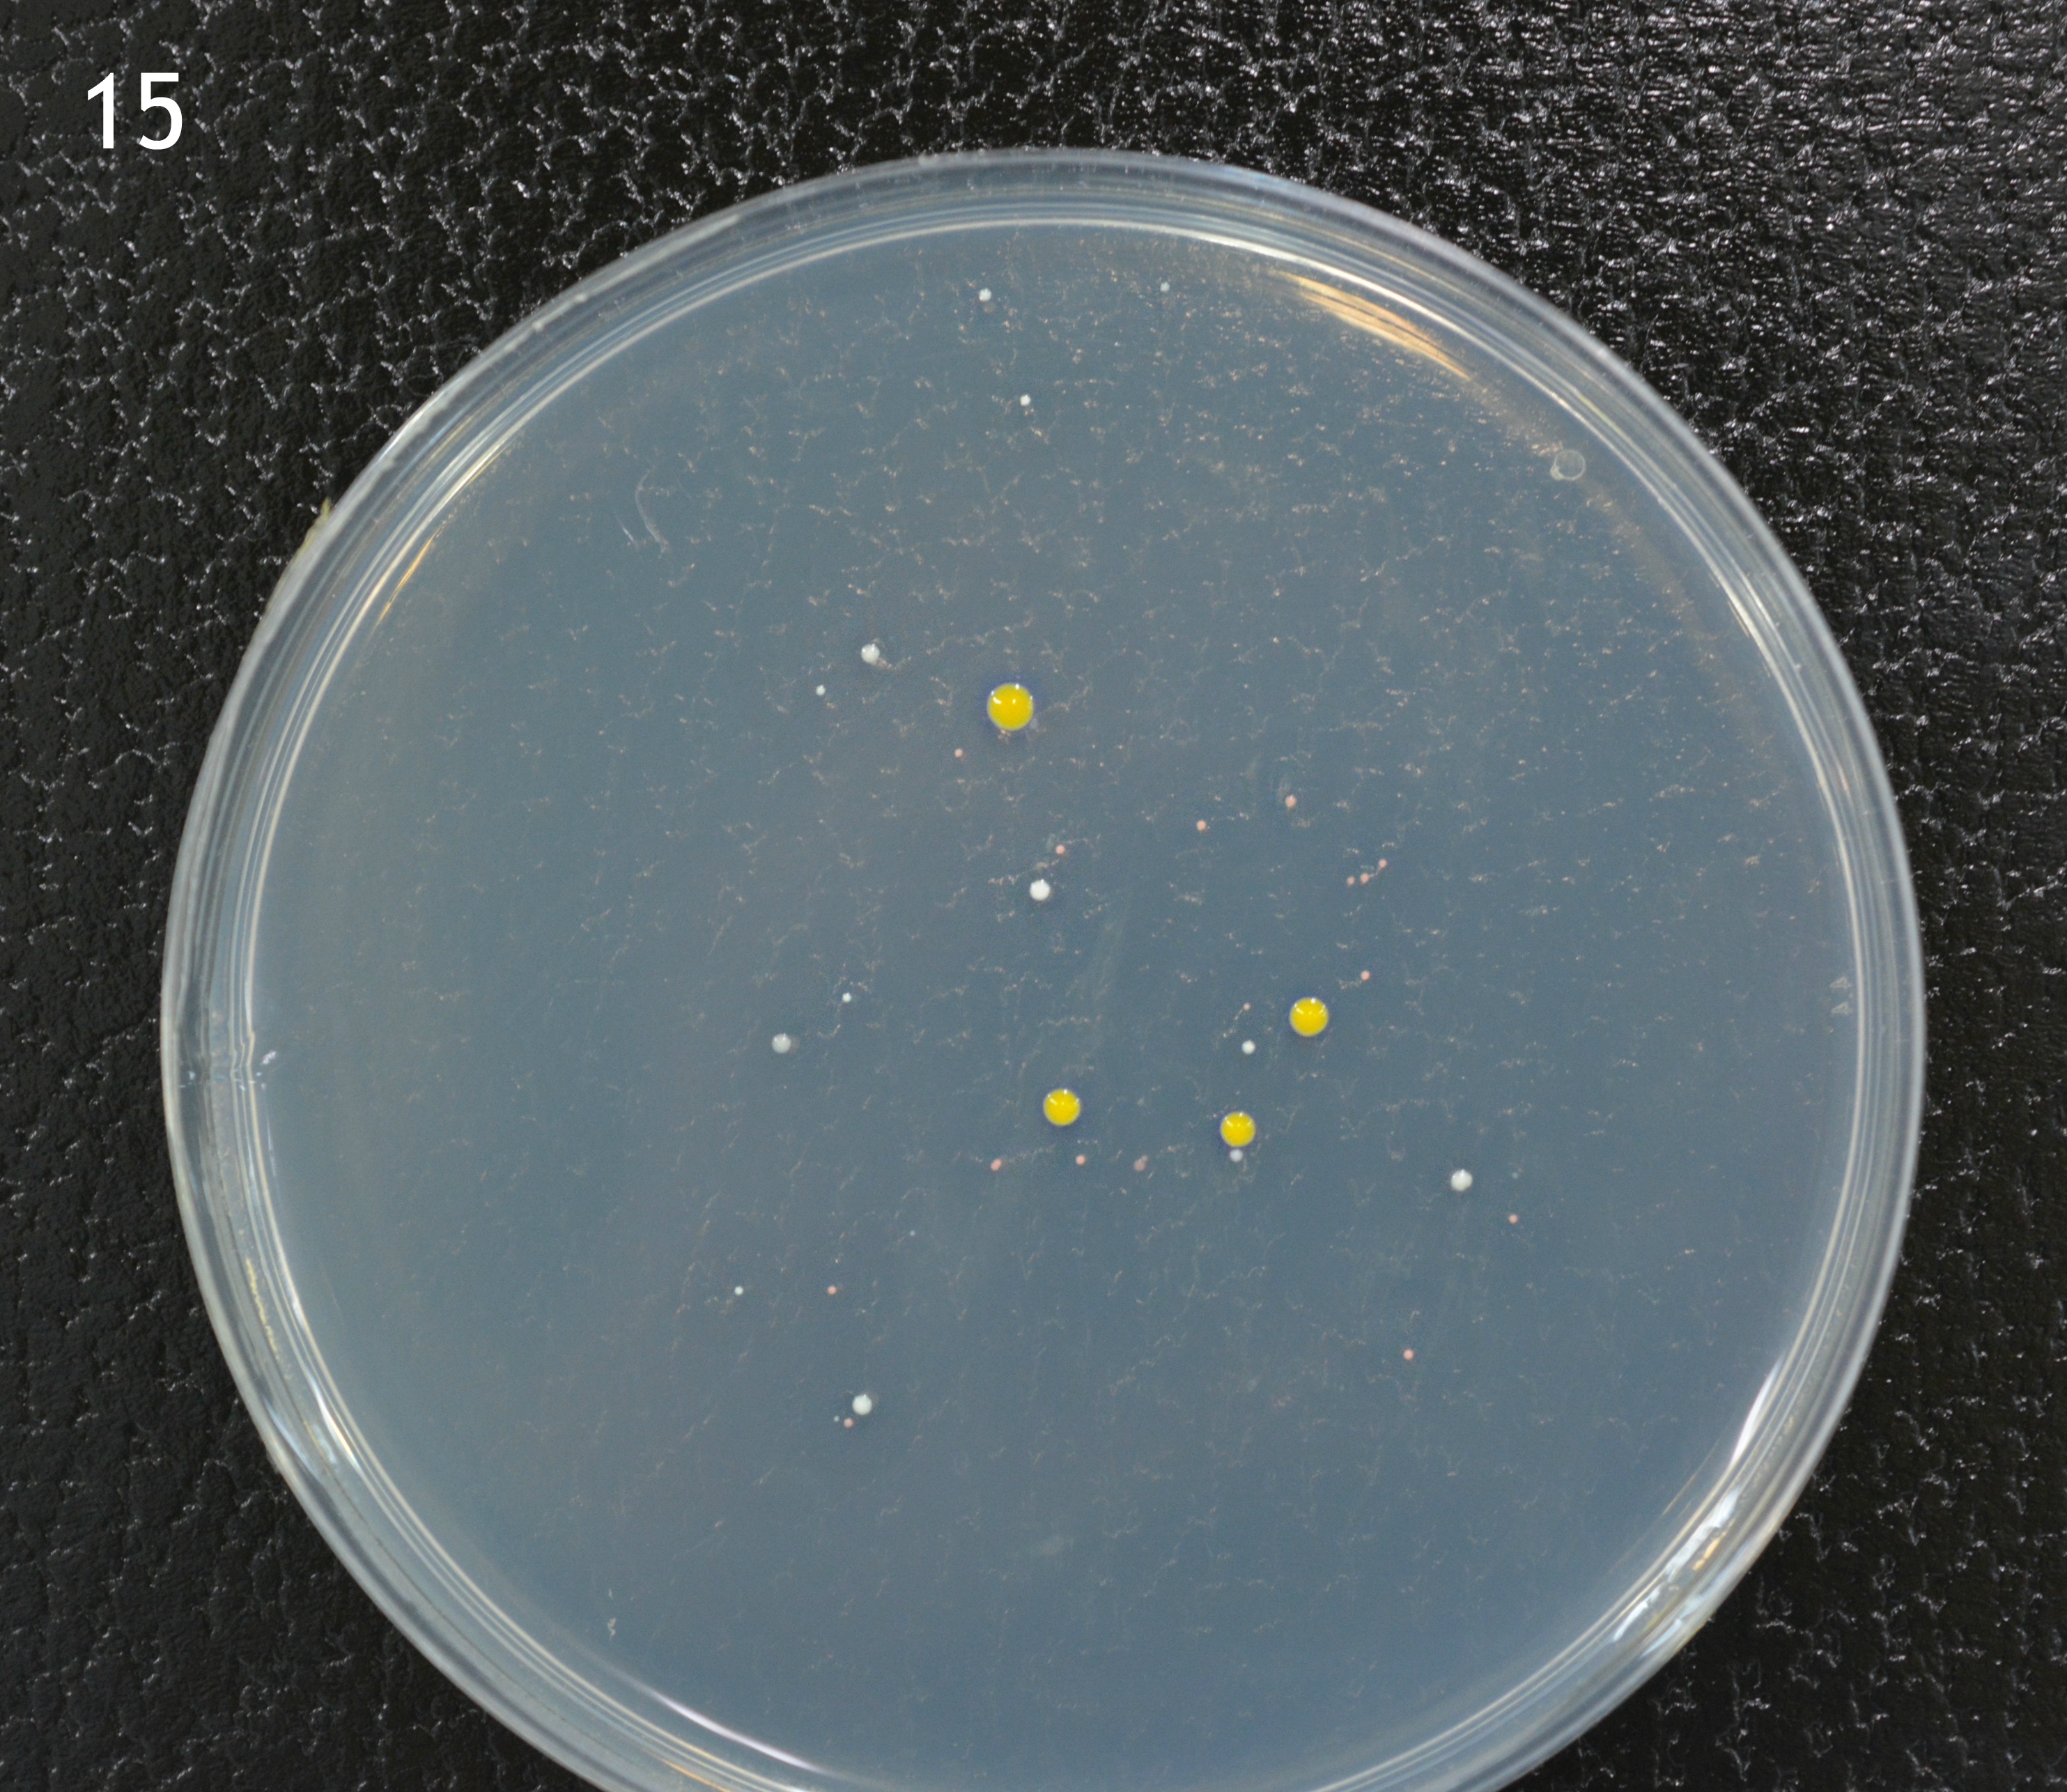

Las personas que hicieron los talleres de salud en Ontinyent pudieron pasar el dedo de la mano por una placa de cultivos y así hacer un cultivo de los microorganismos que tenemos en las manos. En unos días de incubación en una estufa de 37 °C han crecido los siguientes microorganismos:
(recuerda tu número para identificar tu placa)
Imágenes: